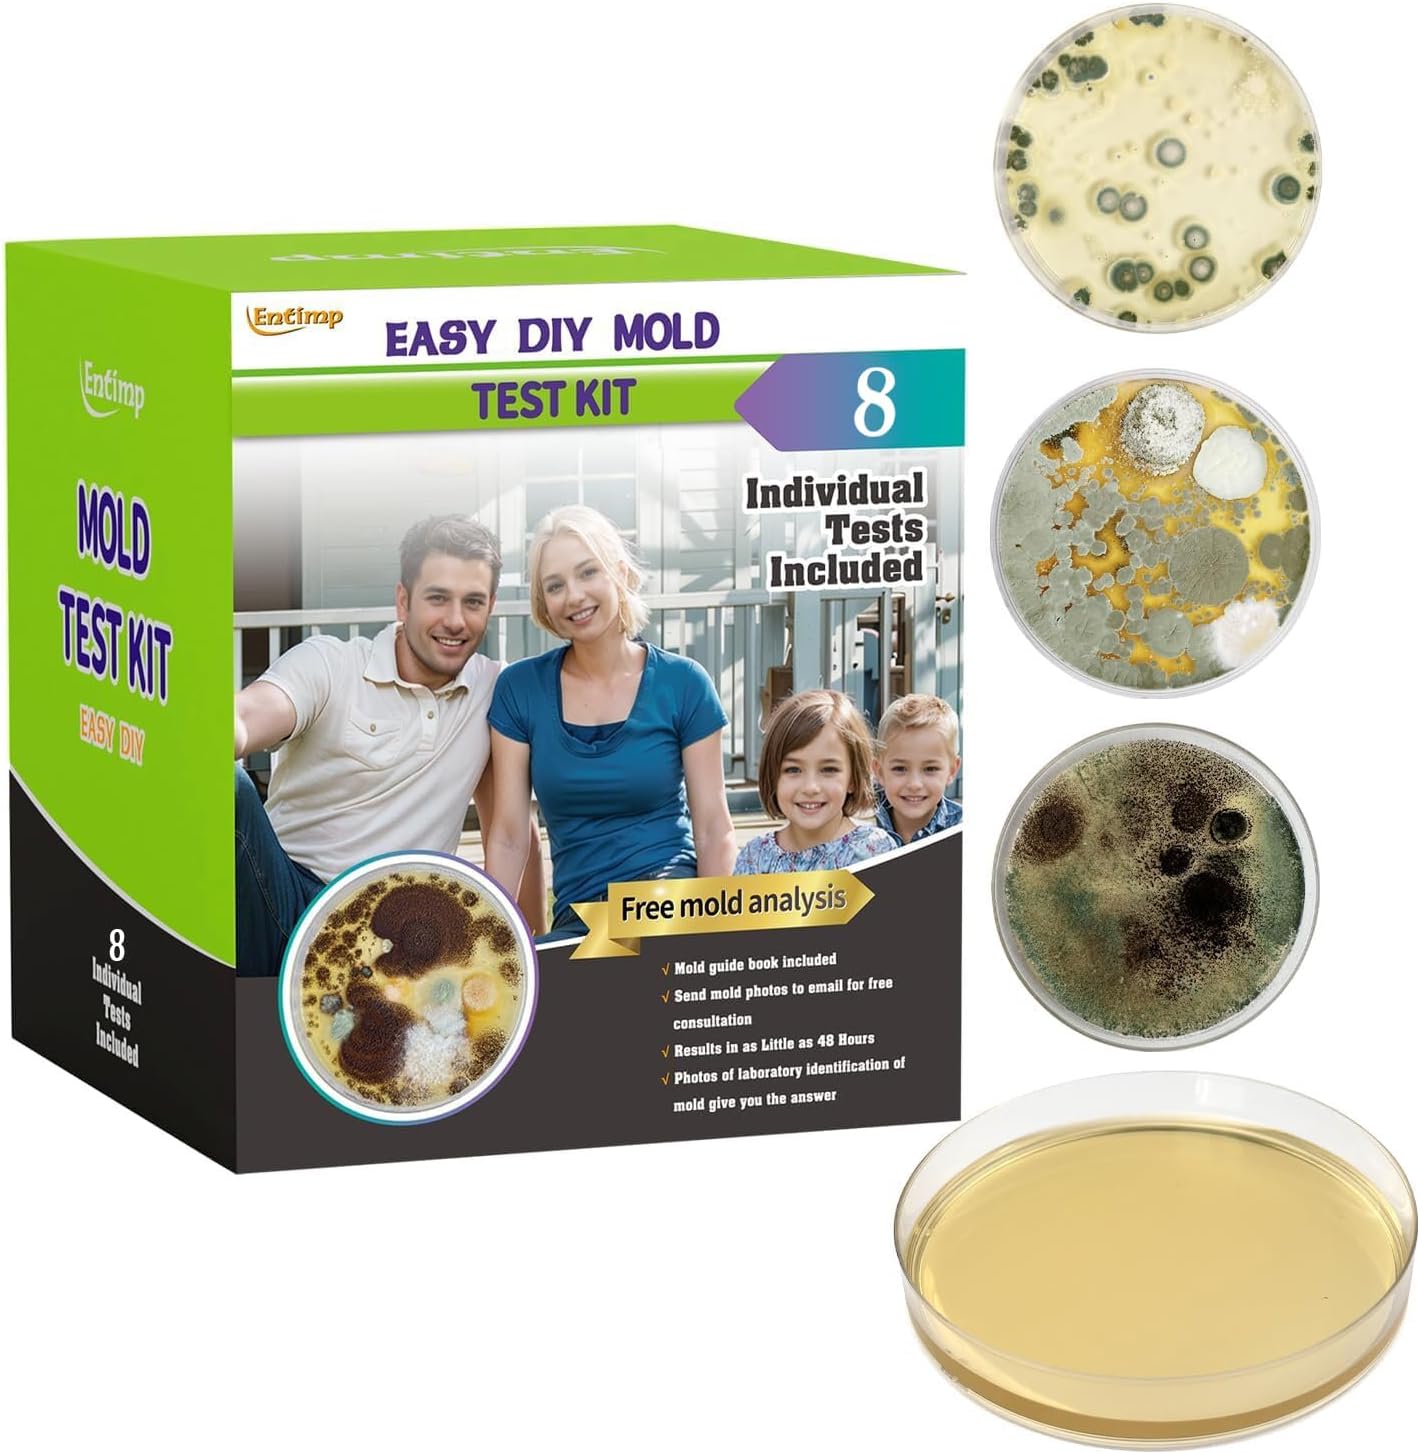
Mold Test Kit for Home Within 8 Individual Tests,DIY Detector at Home,Surface Mold,HVAC,Indoor Air Quality Testing Kits,Black Mold Testing,Includes Detailed Mold Identification Guide and Free Lab

Buy anything from 5,000+ international stores. One checkout price. No surprise fees. Join 2M+ shoppers on Desertcart.
Desertcart purchases this item on your behalf and handles shipping, customs, and support to Ecuador.
🛡️ Mold-free living starts here — test smart, live safe!
The ENTIMP Mold Test Kit offers 8 individual agar petri dishes and 3 versatile testing methods (air, surface, HVAC) to detect mold throughout your home. It includes all necessary tools plus a detailed mold identification guide. Unique to this kit, users can submit photos of samples for free professional lab analysis with results delivered within 24 hours, making mold detection fast, accurate, and convenient. Ideal for proactive homeowners seeking peace of mind and a healthier living environment.









| ASIN | B0DCBNDD5B |
| Best Sellers Rank | #842 in Industrial & Scientific ( See Top 100 in Industrial & Scientific ) #3 in Airflow & Air Quality |
| Date First Available | August 6, 2024 |
| Item Weight | 10.4 ounces |
| Manufacturer | ENTIMP |
| Product Dimensions | 3.54 x 3.6 x 3.54 inches |
F**B
Effective, Very quick response, Professional.
Excellent all-in-one mold test kit! It comes with everything you need—6 agar plates, swabs, gloves, and clear instructions—to test air, surfaces, and HVAC areas throughout the home. I really like the flexibility of the different testing methods, which makes it easy to pinpoint problem spots. The free lab analysis is a huge bonus. Being able to submit photos instead of mailing samples is fast, convenient, and hassle-free. Very quick response, professional.. Overall, this is a high-quality, easy-to-use kit that provides great value and peace of mind. Highly recommended.
M**A
Entimp Mold Test Kit - Invaluable
After noticing some persistent musty odors in our home, I purchased the Entimp Mold Test Kit for Home from Amazon. What began as a simple precautionary measure became an eye-opening discovery about our living environment. This review details my experience with this product and why it offers exceptional value for homeowners concerned about potential mold issues. Product Quality and Contents The Entimp Mold Test Kit arrived promptly and was impressively comprehensive right out of the box. It includes six individual agar Petri dishes, which allowed me to test multiple areas of concern throughout our home. Additionally, it came equipped with all necessary supplies: cotton-tipped swabs, enclosed plastic bags, disposable gloves, label stickers, and a detailed identification and removal guide. The quality of the materials exceeded my expectations, particularly the well-sealed Petri dishes, which are crucial for obtaining accurate results. Everything was clearly labeled and professionally packaged, giving me confidence in the testing process. Ease of Use As someone without specialized knowledge in mold testing, I appreciated the straightforward instructions. The step-by-step guide walked me through the process, from selecting testing locations to collecting samples properly. The kit offers three distinct testing methods (air quality, HVAC system, and surface sampling), providing flexibility based on your specific concerns. I opted to test all the rooms in our home. The sampling process was quick and noninvasive, taking less than an hour to complete all tests. Testing Process and Results After following the instructions and allowing the samples to incubate for seven days, I discovered significant mold growth on several test plates. The visual evidence was concerning but validated my suspicions about a potential mold problem in our home. What truly sets this product apart is what happened next. Instead of packaging and mailing physical samples (as required by many other testing kits), I photographed the results and submitted them directly to Entimp for analysis. This convenient approach saved time and eliminated concerns about samples being compromised during shipping. Professional Analysis and Report Within 24 hours of submitting my photos, I received a detailed report from Entimp's laboratory team that exceeded all my expectations. The analysis was thorough and professional, identifying specific mold types in our home and providing context about potential health implications. The report included: 1. Identification of mold species by genus 2. Concentration levels in each tested area 3. Potential sources of moisture contributing to the growth 4. Health risks associated with the specific molds identified 5. Detailed recommendations for remediation What impressed me most was the report's personalized nature. It didn't feel like a generic template but a customized assessment of our situation. The analysts took time to evaluate our circumstances and provided actionable guidance. Customer Service Excellence Entimp's customer service was exceptional throughout the process. The expertise demonstrated in the written report gave me confidence that I was receiving legitimate, science-based guidance rather than alarmist information designed to sell remediation services. Value and Peace of Mind Discovering we had a mold issue in our home was initially concerning, but having detailed information about the problem empowered us to take appropriate action. The comprehensive nature of the Entimp kit—combining DIY testing with professional analysis—offers exceptional value compared to the cost of hiring a professional inspector for initial screening. Conclusion The Entimp Mold Test Kit proved invaluable in identifying and addressing a hidden health hazard in our home. From the quality of the testing materials to the impressive depth of the analysis report, every aspect of this product exceeded my expectations. For homeowners concerned about potential mold issues, this kit offers an accessible, reliable first step in assessment. It provides meaningful results that homeowners can act upon. The peace of mind alone is worth the investment, but the professional-grade information provided makes this product truly outstanding in its category.
D**E
Great test kit and customer service
I’m very happy with this mold test kit and the service that came with it. The team was reliable, attentive, and incredibly quick to respond to my questions. What really stood out was their willingness to go back and forth over multiple emails to make sure I understood everything clearly. They carefully reviewed the pictures I sent and provided detailed guidance on how to clean the air, properly dehumidify the space, and identify the source of the mold. Their recommendations were practical and easy to follow, which gave me confidence that I was addressing the issue correctly. Overall, I’m extremely satisfied with this purchase. The product works well, and the customer support truly exceeded my expectations. I would definitely buy from them again and highly recommend this kit to friends and family.
R**J
Comprehensive and Convenient - An Excellent Mold Testing Kit!
This mold test kit is an excellent, all-in-one solution for anyone who wants to test their home for mold. It is a truly 5-star product that provides everything you need for a thorough and convenient home test! The kit is incredibly complete, coming with 12 agar petri dishes, swabs, gloves, and all the necessary accessories. This comprehensive package allows you to test for a wide range of mold types in multiple locations, including indoor air, surfaces, and your HVAC system. I love the versatility of the three testing methods, which allows you to perform an air quality test or a direct surface sampling to pinpoint any areas of concern. This adaptable approach ensures a thorough assessment of your home environment. What really sets this kit apart is the included free laboratory analysis. The ability to get professional analysis by simply sending a photo of the results, without the hassle of mailing a physical sample, is a huge convenience. This fast and easy process provides quick peace of mind, and the included mold guide is a great resource for identifying common mold types and learning how to remove them. This kit provides a professional and comprehensive way to test for mold in your home, making the process convenient and accessible. It's a fantastic product for protecting the health and safety of your family.
R**S
Definitely a must for any homeowner, especially if you're just purchased a home! Test it now.
Without doubt, this is hands down the quickest, the easiest, and definitely the most homeowner friendly mold test that I've ever used. As soon as the waiting period was over, I set the Petri dishes out on white paper and took pictures of them all, and I emailed them to the company for evaluation. The evaluation came back later that same day! That's fast. It came with a very concise and easy to understand mold report. I highly recommend this product and this company. How you want? Our house is still relatively new, we've never had any major water leaks or anything like that. I just wanted to have a peace of mind that my home was safe regarding any kind of mold (most of the time you can't see it). This is a very inexpensive way to have peace of mind that nothing is poisoning, myself or my family.
E**O
Great product, easy to use and I like how it has a book on how to identify, clean and dispose of mold. They also offer help from experts to identify mold if you're having troubles
A**R
It takes a few days but did show I needed to take action.
W**J
After having a few issues in my apartment, I decided some testing needed to be done. This test is so easy to do!!! I couldn't really figure out what kind of mold was present so I emailed the company with pictures I had taken. It was exactly an hour later that I got the results. Very impressed with that!! The report is very scary however it was very detailed, explained what to look for, the dangers of each mold found and some suggestions on how it could be treated. I'm totally impressed by their speed of response, the detailed reports and possible resolutions. I am now testing other rooms and look forward to their help again 🙂. Thank you ever so much!! The results explain so much!!!
S**R
We ordered this to do some basic mould testing after experiencing some water damage in our home. The kit alone provided us with an informative booklet of different types of mould that may appear as well as ways to treat it. The 'plates' were easy to use and it was actually quite fascinating watching it grow, from day to day! However, what I believe was REALLY super was their customer service. I was able to send them photos of my samples and get some feedback on our personal samples. I absolutely recommend this product and company. Good quality and service can sometimes be disappointing but these people really do deliver!
U**T
This arrived quickly. Everything you will need to do the testing is included. The booklet is highly informative and the instructions are clear. I did want clarification on my results even though the booklet has great photos. I sent an email with photos of my results and received a very detailed reply with identification of type of mold. Amazing response from this company! I will be purchasing again as well as sharing!
Trustpilot
1 week ago
1 month ago